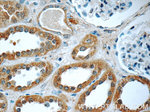
FER Antibody in Immunohistochemistry (Paraffin) (IHC (P))

Search
Proteintech
FER Polyclonal Antibody
{{$productOrderCtrl.translations['antibody.pdp.commerceCard.promotion.promotions']}}
{{$productOrderCtrl.translations['antibody.pdp.commerceCard.promotion.viewpromo']}}
{{$productOrderCtrl.translations['antibody.pdp.commerceCard.promotion.promocode']}}: {{promo.promoCode}} {{promo.promoTitle}} {{promo.promoDescription}}. {{$productOrderCtrl.translations['antibody.pdp.commerceCard.promotion.learnmore']}}
产品信息
25287-1-AP
种属反应
宿主/亚型
分类
类型
抗原
偶联物
形式
浓度
规格
纯化类型
保存液
内含物
保存条件
运输条件
产品详细信息
Immunogen sequence: PLHRLTMMI KDKQQVKKSY IGVHQQIEAE MIKVTKTELE KLKCSYRQLI KEMNSAKEKY KEALAKGKET EKAKERYDKA TMKLHMLHNQ YVLALKGAQL HQNQYYDITL PLLLDSLQKM QEEMIKALKG IFDEYSQITS LVTEEIVNVH KEIQMSVEQI DPSTEYNNFI DVHRTTAAKE QEIEFDTSLL EENENLQANE IMWNNLTAES LQVMLKTLAE ELMQTQQMLL NKEEAVLELE KRIEESSETC EKKSDIVLLL SQKQALEELK QSVQQLRCTE AKFSAQKELL EQKVQENDGK EPPPVVNYEE DARSVTSMER KERLSKFESI RHSIAGIIRS PKSALGSSAL S (96-445 aa encoded by BC017060)
靶标信息
FER is a member of the FPS/FES family of non-receptor tyrosine kinases. It regulates cell-cell adhesion and mediates signaling from the cell surface to the cytoskeleton via growth factor receptors. FER is found in the cytoplasm and in the nucleus, where it was associated with the chromatin fraction. Its ubiquitous expression and its subcellular location indicate that it may be involved in key regulatory processes. The group IV cytoplasmic protein-tyrosine kinase Fer has been linked to cellular signaling responses to many different stimuli, including growth factors and cytokines. Data suggest a biological role for Fer in regulation of leukocyte recruitment during the innate immune response.
仅用于科研。不用于诊断过程。未经明确授权不得转售。
生物信息学
蛋白别名: EC 2.7.10.2; Feline encephalitis virus-related kinase FER; fer (fms/fps related) protein kinase, testis specific 2; fer (fps/fes related) tyrosine kinase; Fujinami poultry sarcoma/Feline sarcoma-related protein Fer; p47; p94-Fer; phosphoprotein NCP94; protein phosphatase 1, regulatory subunit 74; Proto-oncogene c-Fer; proto-oncogene tyrosine-protein kinase Fer; testis-specific tyrosine kinase; tyrosine kinase (FER); Tyrosine kinase 3; Tyrosine-protein kinase Fer; unnamed protein product
基因别名: AV082135; C330004K01Rik; FER; Fert; Fert2; p94-Fer; PPP1R74; TYK3
UniProt ID: (Human) P16591, (Mouse) P70451
Entrez Gene ID: (Human) 2241, (Mouse) 14158